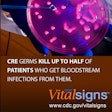

Medical Devices: Page 113
Sustainable Healthcare Packaging Solutions That Work
Industry leaders share proven strategies for reducing packaging emissions by up to 70% while meeting safety and regulatory requirements.
Read More
Researched List: Blister Machines for Life Sciences
Need a blister machine for life sciences packaging? Our curated list features companies serving pharmaceutical, medical device, nutraceutical, and cosmetic industries. Download to access company names, locations, machine specifications, descriptions, and more.
Download Now
Downloads